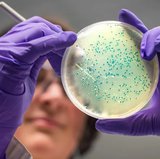

PREDSEDNIK Rusije Vladimirr Putin izjavio je danas da zna šta se događa sa kompanijom NIS i da se nada da će se naći zajedničko rešenje.
- Nažalost, uprkos spoljašnjim naporima da se poboljšaju odnosi, pritisak sankcija, koji je deo politike sa pozicije sile, nesumnjivo se nastavlja. To se tiče i naše kompanije, ‘Gaspromnjeft’, koja je vlasnik NIS-a. To je kompanija u koju je ‘Gaspromnjeft’ uložio značajna sredstva, više od tri milijarde dolara, i transformisao je u savremeno, visoko efikasno preduzeće - istakao je Putin.

Foto: Printscreen
- Znamo šta se događa sa kompanijom NIS. Imamo međudržavni sporazum i polazimo od toga da će prijateljsko srpsko rukovodstvo to imati u vidu. Imamo predstavu u kom pravcu želimo da zajedno idemo dalje. Radimo na tome i nadam se da ćemo naći potrebno rešenje - rekao je ruski predsednik, prenosi Sputnjik.


Autor: Novosti.rs